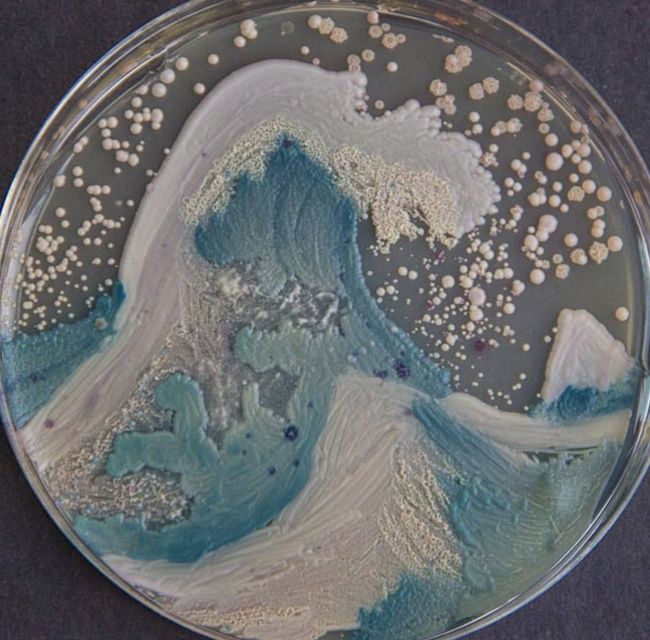

O que é a perfeição pra você? Essa é uma resposta que abre um leque com infinitas possibilidades que, muitas vezes, não conseguimos chegar em uma única resposta, afinal, muitas coisas podem servir como exemplo.
A fotografia, inclusive, é uma delas, existem imagens que realmente enchem os nossos olhos, como é o caso dessas 12 fotos que mostram como algumas coisas são realmente perfeitas:
01. As glicínias no Japão são encantadoras
02. E neva na primavera de Maryland, Estados Unidos
03. Incrível: um raio visto de muito perto
04. Uma bola de tênis voando
05. Show de fogos de artifícios no Japão
06. Biblioteca em Dublim, Irlanda
07. Pintarroxo, o pássaro com cor de algodão doce
08. Em meio a um nevoeiro suíço
09. A tempestade chegando no campo
10. Imagem em uma placa de Petri
11. Um deserto em Namibe
12. Uma ponte ou obra de arte?